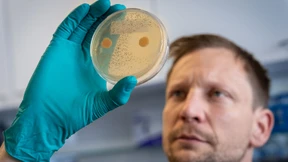
Auf der Suche nach neuen Heilmitteln in alten Pilzkulturen

Sanofi strebt Großinvestition in Frankfurt an
In ein neues Insulinwerk in Frankfurt könnten bis zu 1,5 Milliarden Euro fließen. Die Bundesregierung sieht sich in ihrem Kurs bestätigt.

In ein neues Insulinwerk in Frankfurt könnten bis zu 1,5 Milliarden Euro fließen. Die Bundesregierung sieht sich in ihrem Kurs bestätigt.

Der französische Pharma-Riese Sanofi will in Frankfurt mehr als eine Milliarde Euro investieren. Der Wandel macht auch vor dem Handel keinen Halt. Und am Mainzer Staatstheater kommt der „Rosenkavalier“ mit Knallfarben und Kitsch daher. Die F.A.Z.-Hauptwache blickt auf die Themen des Tages.

Der Pharmakonzern plant in Höchst den Bau einer neuen Produktion für Insulin. Das ist in doppelter Hinsicht wichtig für den Standort.

Der Pharmakonzern Sanofi plant eine milliardenschwere Investition in eine neue Insulinproduktion in Frankfurt. Dies ist nicht nur eine großartige Nachricht für die Stadt, sondern auch ein Beweis für die wirtschaftliche Bedeutung des Standorts.

Der Pharmakonzern Sanofi plant im Frankfurter Stadtteil Höchst den Bau einer neuen Produktion für Insulin. Das ist in doppelter Hinsicht wichtig für den Standort.

Zwei Wissenschaftler arbeiten an einem Medikament, das Menschen mit Chronischem Fatigue-Syndrom heilen soll. Hätten sie Erfolg, könnte es Hunderttausenden helfen – und wäre entsprechend lukrativ.

Am Dienstag endet der Ramadan und damit für manche Unternehmen eine Zeit etwas anderer Personalplanung und eine Durststrecke bei den Umsätzen.

Belén Garijo ist in der Corona-Pandemie mit viel Rückenwind als erste Merck-Chefin gestartet. Nun häufen sich die Herausforderungen – vor allem auf dem Feld ihrer Expertise.

Der Rückenwind für Aktien ist zunächst etwas abgeflaut. Doch können konservativ orientierte Anleger mit der richtigen Aktienauswahl durchaus einträgliche Renditen erzielen.

Zur Jahreswende richtet sich der Blick stets in die Zukunft. Die Wirtschaftsredaktion der Rhein-Main-Zeitung hat deshalb für wichtige Unternehmenslenker aus Rhein-Main und auch den künftigen hessischen Wirtschaftsminister die Karten gelegt – und dabei so einiges über 2024 herausgefunden.

Leserkommentar zu: Bitterer Jahrestag für „Hoechster““, F.A.Z. vom 2. Dezember

In der Industrie, aber auch bei Dienstleistern kann nur ein Teil der Belegschaft zuhause arbeiten. Manche finden das ungerecht. Wie Unternehmen damit umgehen.
Der französische Pharmakonzern konzentriert sich auf Forschung und Entwicklung und will insgesamt zwölf Projekte mit Blockbuster-Potential vorantreiben. Kostspielige Phase-3-Studien wird es so einige geben müssen.
Drei deutsche Pharma-Hoffnungen haben sich binnen weniger Wochen jäh zerschlagen. Für den Standort ist das ein Alarmsignal.

Die Abspaltung von Sanofis Consumer-Healthcare-Sparte nimmt Konturen an. An der Börse wird der Konzern abgestraft.

Der Chef des Industrieparks Höchst befürchtet, dass Betriebe Deutschland wegen hoher Energiekosten verlassen. Im Interview wirbt Joachim Kreysing für einen vergünstigten Strompreis für Teile der Chemiebranche.
Sanofi hat seine Kapazitäten zur Herstellung von Grippeimpfstoffen erfolgreich ausgebaut – und eine neue Deutschland-Chefin.

Der Chef eines der größten Industrieparks in Deutschland warnt, dass Unternehmen wegen der Energiepreise Produktion verlagern. Das wäre verheerend. Die Lösung, die Infraserv-Geschäftsführer Kreysing vorschlägt, ist aber nicht hilfreich.

Jochen Maas geht nach mehr als zehn Jahren als Forschungsleiter bei Sanofi in den Ruhestand. Im Interview spricht er über die Probleme der Branche mit der deutschen Bürokratie.

Die Diagnose Diabetes kam früher einem Todesurteil gleich. Dann wurde Insulin entdeckt. Eine der wichtigsten Produktionsstätten befindet sich seitdem in Frankfurt-Höchst.
Das Unternehmen aus Bad Vilbel erwirbt die Rechte an verschiedenen Marken des französischen Konzerns.

Nach der Impfstoffschlappe in der Corona-Pandemie strotzt der französische Pharmariese Sanofi vor Zuversicht. Zehn Milliarden Euro Umsatz peilen die Franzosen im Jahr 2030 für ihre Vakzinsparte an.

Das Diabetes-Medikament Semaglutid wurde als Wundermittel gegen Übergewicht gepriesen. Nun sieht die Europäische Arzneimittelagentur Hinweise, dass die Arznei das Krebsrisiko erhöhen könnte.

Der J.P.-Morgan-Lauf in Frankfurt ist für viele Unternehmen eine Gelegenheit zu feiern. Nach der Corona-Delle steigt die Teilnehmerzahl wieder.
Das Fraunhofer-Institut in Gießen verwahrt eine Sammlung von Pilzen und Bakterien, die einst dem Sanofi-Konzern gehörte. Forscher fahnden darin nach unentdeckten Naturstoffen, mit denen sich Krankheiten bekämpfen lassen.

Die Spezialmedizin ist erstmals die wichtigste Konzernsparte des französischen Pharmariesen. Das Unternehmen verneint eine zu große Abhängigkeit.

Das Umfeld für Aktieninvestments hat sich etwas verbessert. Eine Aktiendividendenstrategie sollte in diesem Jahr eine gute Chance auf eine brauchbare Gesamtrendite liefern.

Schafft die einstige deutsche Impfstoffhoffnung den Neuanfang? Studiendaten machen Hoffnung, die Aktie steigt, jetzt kommt ein neuer Chef.

Schafft die ehemalige deutsche Impfstoffhoffnung endlich den Neuanfang? Neue Studiendaten machen Hoffnung, der Aktienkurs steigt rasant, jetzt kommt auch noch ein neuer Chef.
Horizon-Gründer leidet selbst an seltenen Autoimmunkrankheiten

Mit Hilfe von Künstlicher Intelligenz will der Pharmakonzern Sanofi die Entwicklung von Wirkstoffen deutlich beschleunigen und verbilligen. Die Frankfurter wollen dafür die Schwarmintelligenz der globalen Forschergemeinde anzapfen.

Die Sieben-Tage-Inzidenz sank nach Angaben des Robert-Koch-Instituts in allen Bundesländern. Im Wochenvergleich betrug der Rückgang 35 Prozent. Dabei spielen auch Schulferien eine Rolle.
Dupixent bleibt für den französischen Pharmakonzern Sanofi ein Kassenschlager. Vor allem in den USA ist das Asthma- und Neurodermitis-Medikament gefragt.

Bleiben die Lastwagen stehen? Bunkert Sanofi Harnstoff? Unsere Gesellschaft ist vernetzter, als manch vorschneller Jubel glauben machen mag. Es lohnt der zweite Blick.

Die jüngsten Kursverluste sind für den Vorstandschef von Europas größtem Pharmakonzern Sanofi, Paul Hudson, kein Grund zur Beunruhigung.
Sanofi muss die Sorgen ernst nehmen – von Verbrauchern und von Anlegern.